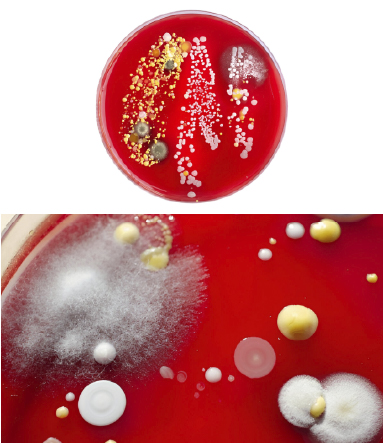
img Bacteriologia y Micologia

Bacteriología y Micología
Diagnóstico preciso y servicios especializados en microbiología veterinaria
SOBRE EL LABORATORIO
La función de la sección de Bacteriología y Micología es desarrollar las actividades académicas y de extensión universitaria y proyección social en el campo de la Bacteriología y Micología veterinaria, y el diagnóstico de salud animal relacionado a ellas.
Nuestro laboratorio está equipado con tecnología de punta y personal altamente calificado para proporcionar servicios de diagnóstico preciso y confiable en microbiología veterinaria.
Promovemos la cultura de la calidad de acuerdo al ISO IEC 25, y velamos por la salud animal y salud pública a través de los servicios de diagnóstico.
SERVICIOS QUE OFRECEMOS
Cultivos, Aislamiento e Identificación
- Cultivos, aislamiento e identificación bacteriana (aerobios y anaerobios) y de hongos
- Identificación bacteriana bioquímica: API 20E, API 20NE, API 20
- Pruebas de sensibilidad microbiana (antibiograma) y preparación de sensidiscos
- Análisis de agua y alimento (conteo y número más probable): mesófilos, mohos, levaduras, E. Coli, Clostridium spp., y Staphylococcus spp.
Pruebas Serológicas
- Mycoplasma hyopneumoniae (ELISA)
- Actinobacillus pleuroneumoniae (ELISA)
- Lawsonia intracellularis (IFI)
Aislamiento de Hongos
- Cultivo y tipificación de hongos
Molecular
- Patotipos de Escherichia coli por PCR
- E. coli toxigénica (Enfermedad del edema)
- Clostridium perfringens por PCR
- Clasificación toxinotípica de C. perfringens
- Clostridium difficile (toxinas A y B) por PCR
- Leptospira spp. por PCR
- Mycoplasma hyopneumoniae por RT-PCR
- Mycoplasma hyorhinis por RT-PCR
Neumonías
- Pasteurella multocida
- Bordetella spp
Poliserositis
- Glaesserella parasuis
- Actinobacillus pleuroneumoniae
- Streptococcus suis
Aislamiento e Identificación Bioquímica
- Bacterias aerobias
- Bacterias anaerobias y microaerófilas
- Clostridium spp
- Descarte enfermedad de Glasser (Haemophilus sp y Actinobacillus sp)
- Salmonella spp
- Taylorella equigenitalis
Pruebas de Sensibilidad
- En agar, bacterias aerobias
- En agar, bacterias anaerobias
- En agar, Glaesserella parasuis y Actinobacillus sp
- Preparación de discos de antibióticos
Análisis de Agua, Alimento e Insumos
- Recuento en placa de bacterias mesófilas aerobias
- Recuento en placa de coliformes
- Recuento de Escherichia coli
- Numeración de mohos y levaduras
- Numeración de Salmonella spp
Serología (Detección de Anticuerpos)
- Brucella abortus, B. melitensis y B. suis (Rosa de Bengala)
- Leptospira sp (MAT) por 12 serovares
- Leptospira sp (MAT) por 6 serovares
- Mycoplasma hyopneumoniae (ELISA)
Análisis de Agua, Alimento e Insumos
- Recuento en placa de bacterias mesófilas aerobias
- Recuento en placa de coliformes
- Recuento de Escherichia coli
- Numeración de mohos y levaduras
- Numeración de Salmonella spp
Serología (Detección de Anticuerpos)
- Brucella abortus, B. melitensis y B. suis (Rosa de Bengala)
- Leptospira sp (MAT) por 12 serovares
- Leptospira sp (MAT) por 6 serovares
- Mycoplasma hyopneumoniae (ELISA)
Coloraciones
- Azul de metileno y coloración Gram
- Coloración de esporas (Clostridium spp y Bacillus sp)
Otras Pruebas
- Evaluación de desinfectantes (prueba de eficacia – Carrier Test)
COMPROMISO CON LA CALIDAD
Norma ISO IEC 25
Nuestro laboratorio promueve la cultura de la calidad de acuerdo a la norma ISO IEC 25, garantizando la confiabilidad y precisión de nuestros resultados.
"Velamos por la salud animal y salud pública a través de servicios de diagnóstico de alta calidad, precisión y confiabilidad, contribuyendo al bienestar de la comunidad y al desarrollo sostenible del sector pecuario."
CONTACTO Y ATENCIÓN
DirecciónSD
Av. Circunvalación Cuadra 28 - San Borja, Lima - Perú
Teléfono
+51 (01) 6197000 Anexo 5001
laboratorios.veterinaria@unmsm.edu.pe






